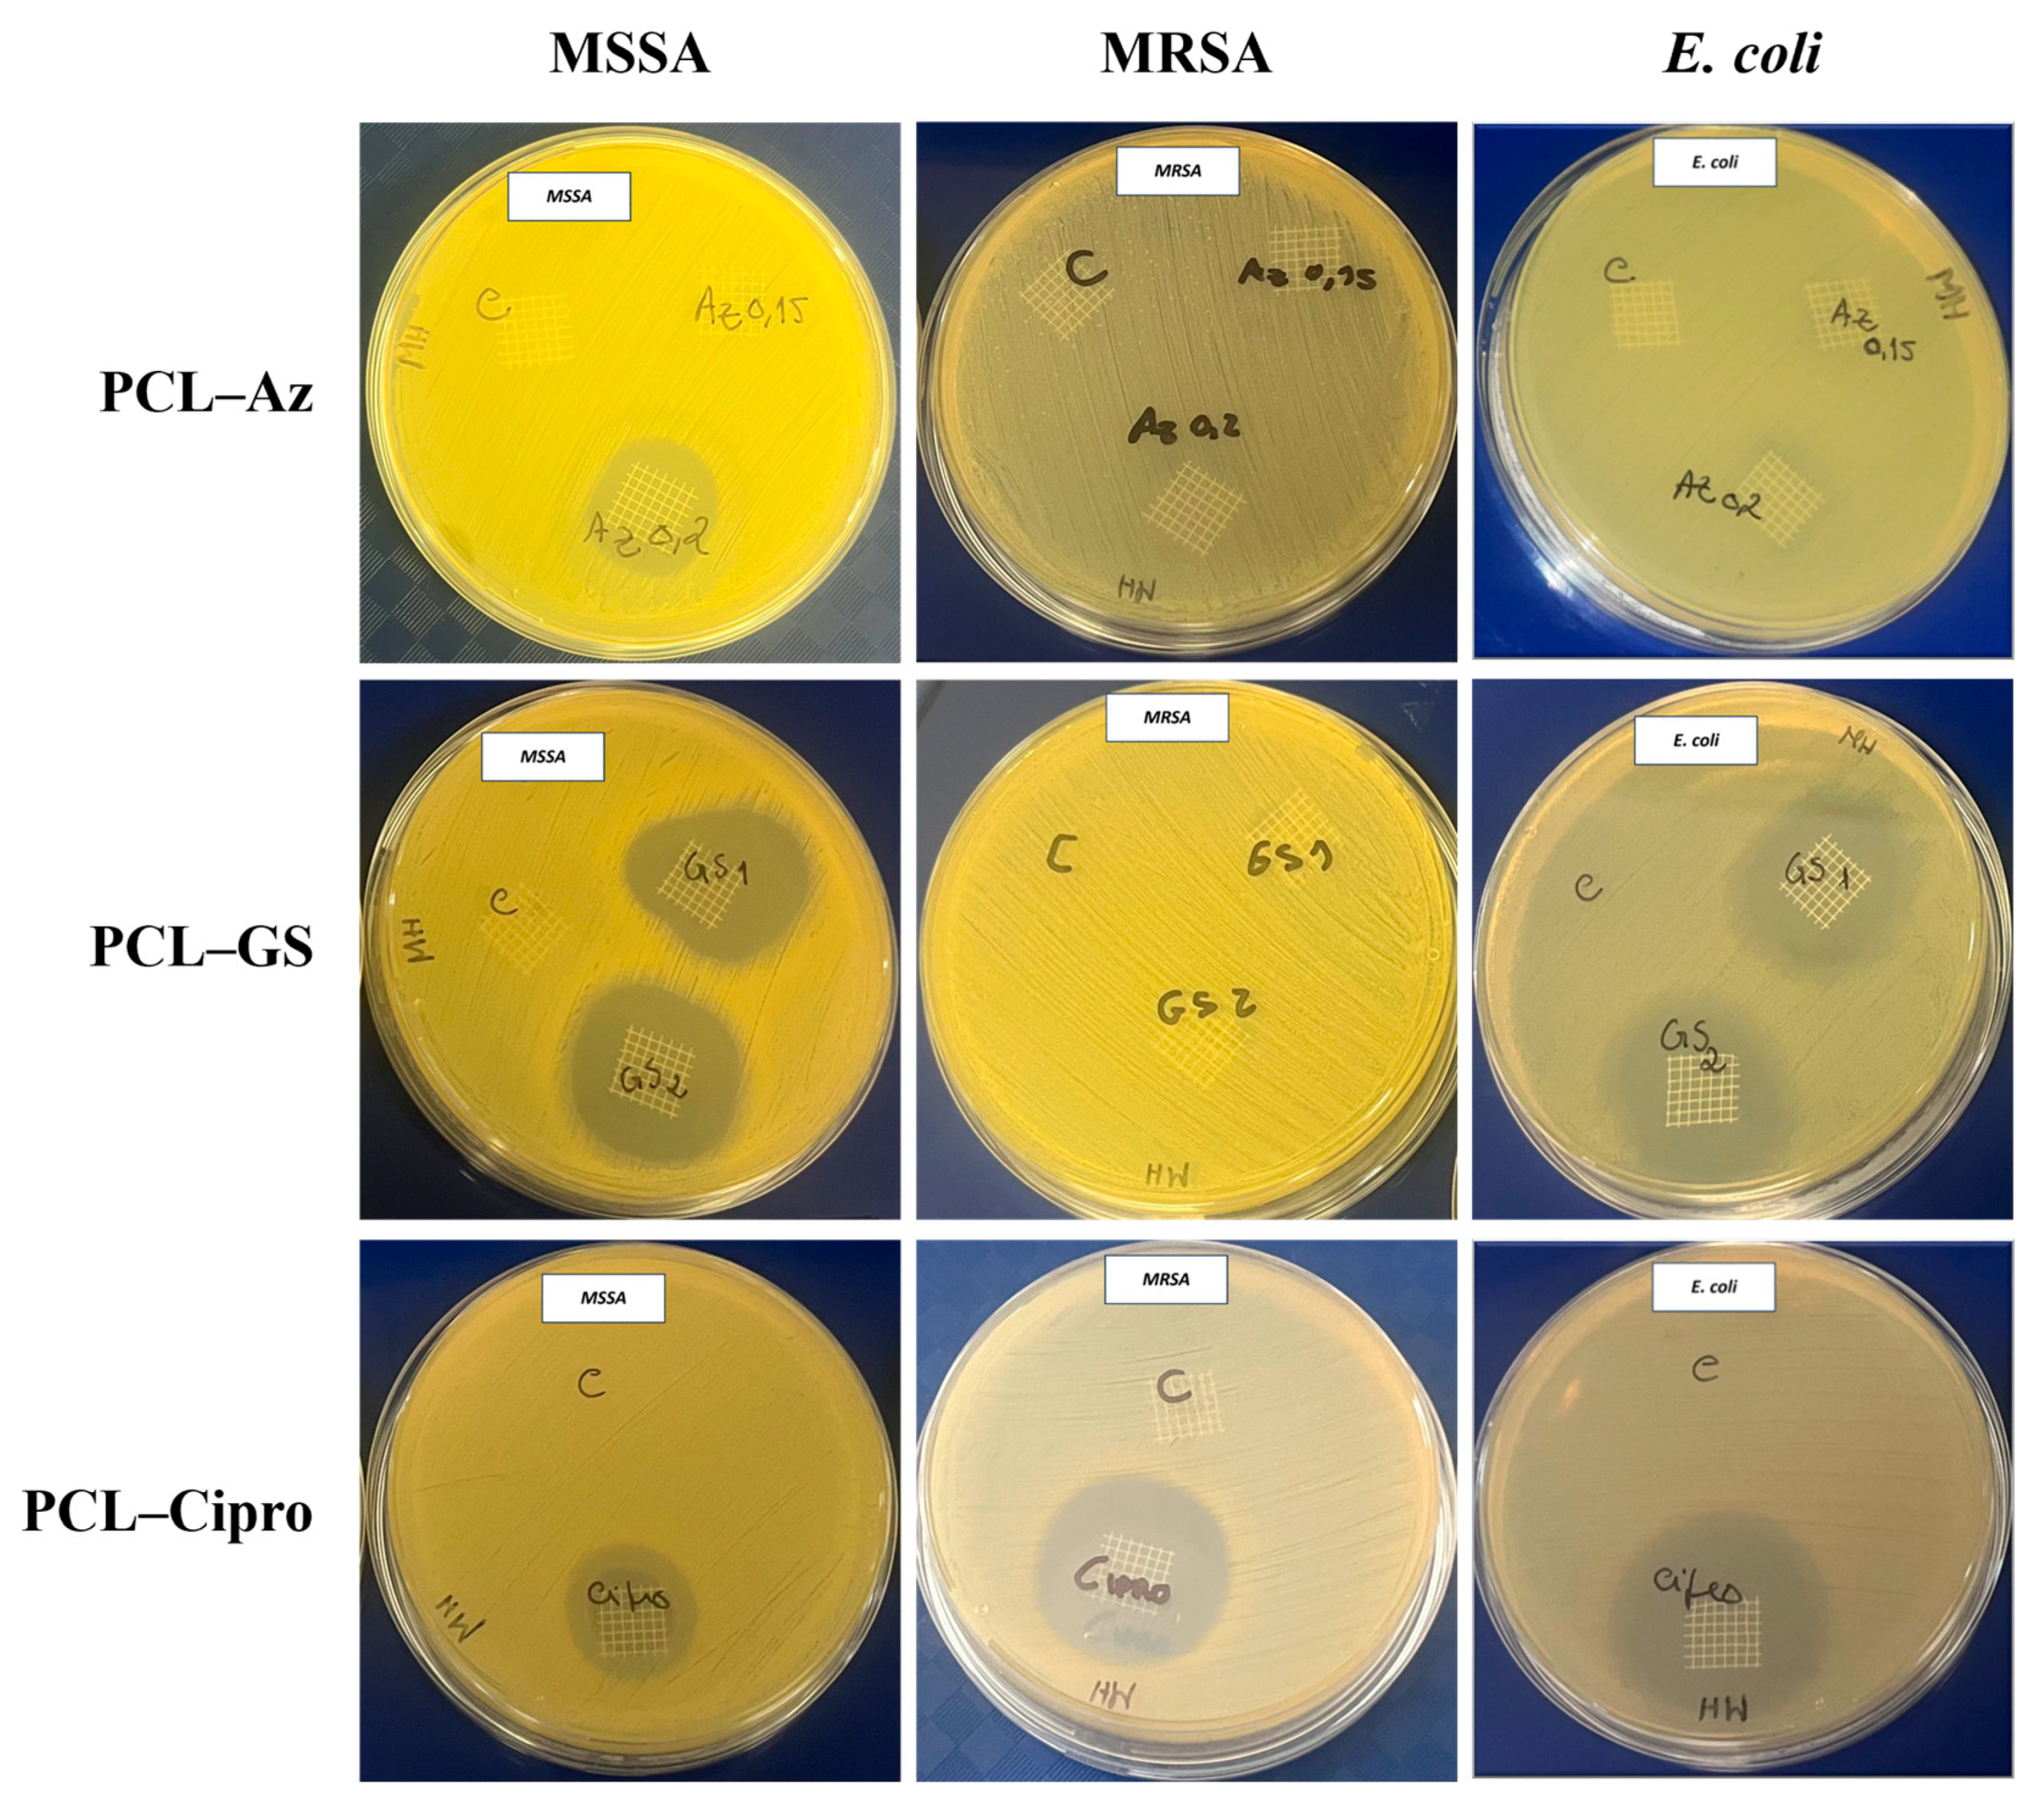
Macromol 05 00033 g004

Antibiotic-Coated Melt Electrowritten Polycaprolactone Meshes: Fabrication and In Vitro Antibacterial Evaluation
Abstract
1. Introduction
2. Materials and Methods
2.1. Production of Polycaprolactone Meshes
2.2. Uniaxial Tensile Tests
2.3. Preparation of PCL Mesh Implants Loaded with Antibiotic Agents
2.4. FTIR Analysis of Antibiotic-Loaded PCL Mesh Implants
2.5. In Vitro Microbiological Assays
2.5.1. Zone Inhibition Assay
2.5.2. Biofilm Formation Assays
2.5.3. Scanning Electron Microscopy (SEM)
3. Results
3.1. Uniaxial Tensile Tests
3.2. Preparation of PCL Mesh Implants Loaded with Antibiotic Agents
3.3. In Vitro Microbiological Assays
3.3.1. Zone Inhibition Assay
3.3.2. Biofilm Formation Assays
3.3.3. Comparative Analysis of Antibacterial Selectiveness
4. Discussion
5. Conclusions
Author Contributions
Funding
Data Availability Statement
Acknowledgments
Conflicts of Interest
Abbreviations
| PFD | Pelvic Floor Dysfunctions |
| POP | Pelvic Organ Prolapse |
| SUI | Stress Urinary Incontinence |
| FDA | Food and Drug Administration |
| UTI | Urinary Tract Infection |
| PP | Propylene |
| MRSA | Methicillin-Resistant Staphylococcus Aureus |
| MSSA | Methicillin-Susceptible Staphylococcus Aureus |
| AM | Additive Manufacture |
| ES | Electrospinning |
| MEW | Melt Electrowriting |
| Cipro | Ciprofloxacin |
| GS | Gentamicin Sulfate |
| Az | Azithromycin |
| FTIR | Fourier Transform Infrared Spectroscopy |
| ATR | Attenuated Total Reflectance |
| SEM | Scanning Electron Microscopy |
| XTT | Tetrazolium Salt |
| CV | Crystal Violet |
| PBS | Phosphate-Buffered Saline |
| OD | Optical Density |
| HPLC | High-Performance Liquid Chromatography |
| DSC | Differential Scanning Calorimetry |
References
- Iglesia, C.B.; Smithling, K.R. Pelvic Organ Prolapse. Am. Fam. Physician 2017, 96, 179–185. [Google Scholar] [PubMed]
- Smith, T.A.; Poteat, T.A.; Shobeiri, S.A. Pelvic organ prolapse. J. Am. Acad. Physician Assist. 2014, 27, 20–24. [Google Scholar] [CrossRef] [PubMed]
- Weber, A.M.; Richter, H.E. Pelvic Organ Prolapse. Obstet. Gynecol. 2005, 106, 615–634. [Google Scholar] [CrossRef] [PubMed]
- Jelovsek, J.E.; Maher, C.; Barber, M.D. Pelvic organ prolapse. Lancet 2007, 369, 1027–1038. [Google Scholar] [CrossRef] [PubMed]
- Ko, K.J.; Lee, K.-S. Current surgical management of pelvic organ prolapse: Strategies for the improvement of surgical outcomes. Investig. Clin. Urol. 2019, 60, 413. [Google Scholar] [CrossRef] [PubMed]
- Dällenbach, P. To mesh or not to mesh: A review of pelvic organ reconstructive surgery. Int. J. Womens Health 2015, 7, 331–343. [Google Scholar] [CrossRef] [PubMed]
- Falagas, M.E.; Velakoulis, S.; Iavazzo, C.; Athanasiou, S. Mesh-related infections after pelvic organ prolapse repair surgery. Eur. J. Obstet. Gynecol. Reprod. Biol. 2007, 134, 147–156. [Google Scholar] [CrossRef] [PubMed]
- Maher, C.; Feiner, B.; Baessler, K.; Schmid, C. Surgical management of pelvic organ prolapse in women. In Cochrane Database of Systematic Reviews; Maher, C., Ed.; John Wiley & Sons, Ltd.: Chichester, UK, 2013. [Google Scholar] [CrossRef]
- Sand, P.K.; Koduri, S.; Lobel, R.W.; Winkler, H.A.; Tomezsko, J.; Culligan, P.J.; Goldberg, R. Prospective randomized trial of polyglactin 910 mesh to prevent recurrence of cystoceles and rectoceles. Am. J. Obstet. Gynecol. 2001, 184, 1357–1364. [Google Scholar] [CrossRef] [PubMed]
- Yuan, M.; Hu, M.; Dai, F.; Fan, Y.; Deng, Z.; Deng, H.; Cheng, Y. Application of synthetic and natural polymers in surgical mesh for pelvic floor reconstruction. Mater. Des. 2021, 209, 109984. [Google Scholar] [CrossRef]
- Mancus1o, E.; Downey, C.; Doxford-Hook, E.; Bryant, M.G.; Culmer, P. The use of polymeric meshes for pelvic organ prolapse: Current concepts, challenges, and future perspectives. J. Biomed. Mater. Res. B Appl. Biomater. 2020, 108, 771–789. [Google Scholar] [CrossRef] [PubMed]
- Baylón, K.; Rodríguez-Camarillo, P.; Elías-Zúñiga, A.; Díaz-Elizondo, J.A.; Gilkerson, R.; Lozano, K. Past, Present and Future of Surgical Meshes: A Review. Membranes 2017, 7, 47. [Google Scholar] [CrossRef] [PubMed]
- Food and Drug Administration. Urogynecologic Surgical Mesh Implants n.d. Available online: https://www.fda.gov/medical-devices/implants-and-prosthetics/urogynecologic-surgical-mesh-implants (accessed on 12 March 2025).
- Rynkevic, R.; Silva, M.E.T.; Martins, P.; Mascarenhas, T.; Alves, J.L.; Fernandes, A.A. Characterisation of polycaprolactone scaffolds made by melt electrospinning writing for pelvic organ prolapse correction—A pilot study. Mater. Today Commun. 2022, 32, 104101. [Google Scholar] [CrossRef]
- Mangir, N.; Roman, S.; Chapple, C.R.; MacNeil, S. Complications related to use of mesh implants in surgical treatment of stress urinary incontinence and pelvic organ prolapse: Infection or inflammation? World J. Urol. 2020, 38, 73–80. [Google Scholar] [CrossRef] [PubMed]
- Mellano, E.M.; Nakamura, L.Y.; Choi, J.M.; Kang, D.C.; Grisales, T.; Raz, S.; Rodriguez, L.V. The Role of Chronic Mesh Infection in Delayed-Onset Vaginal Mesh Complications or Recurrent Urinary Tract Infections. Female Pelvic. Med. Reconstr. Surg. 2016, 22, 166–171. [Google Scholar] [CrossRef] [PubMed]
- Boulanger, L.; Boukerrou, M.; Rubod, C.; Collinet, P.; Fruchard, A.; Courcol, R.J.; Cosson, M. Bacteriological analysis of meshes removed for complications after surgical management of urinary incontinence or pelvic organ prolapse. Int. Urogynecol. J. 2008, 19, 827–831. [Google Scholar] [CrossRef] [PubMed]
- Feng, C.H.; Stevenson, D.D.; Kahn, B.; Higginbottom, P.A. Methicillin-resistant Staphylococcus aureus pelvic abscesses in a female after gynecologic pelvic surgery. Am. J. Obstet. Gynecol. 2011, 205, e4–e5. [Google Scholar] [CrossRef] [PubMed]
- Shah, H.N.; Badlani, G.H. Mesh complications in female pelvic floor reconstructive surgery and their management: A systematic review. Indian J. Urol. 2012, 28, 129–153. [Google Scholar] [CrossRef] [PubMed]
- Mardina, Z.; Venezuela, J.; Maher, C.; Shi, Z.; Dargusch, M.S.; Atrens, A. Design, mechanical and degradation requirements of biodegradable metal mesh for pelvic floor reconstruction. Biomater. Sci. 2022, 10, 3371–3392. [Google Scholar] [CrossRef] [PubMed]
- Kalelkar, P.P.; Riddick, M.; García, A.J. Biomaterial-based delivery of antimicrobial therapies for the treatment of bacterial infections. Nat. Rev. Mater. 2022, 7, 39–54. [Google Scholar] [CrossRef] [PubMed]
- Pfizer Labs. Zithromax® (Azithromycin) for Injection, for Intravenoususe. US Food and Drug Administration, 2022 n.d. Available online: https://www.accessdata.fda.gov/drugsatfda_docs/label/2022/050733Orig1s049lbl.pdf (accessed on 12 March 2025).
- Ward, K.; Theiler, R.N. Once-daily Dosing of Gentamicin in Obstetrics and Gynecology. Clin. Obstet. Gynecol. 2008, 51, 498–506. [Google Scholar] [CrossRef] [PubMed]
- Christian, J.S. The quinolone antibiotics. Prim. Care Update Ob. Gyns. 1996, 3, 87–92. [Google Scholar] [CrossRef]
- Castro, F.J.C.; Yuste, Y.; Pereira, S.; Garvín, M.D.; García, M.Á.L.; Padillo, F.J.; Portilla, F. Proof of concept, design, and manufacture via 3-D printing of a mesh with bactericidal capacity: Behaviour in vitro and in vivo. J. Tissue Eng. Regen. Med. 2019, 13, 1955–1964. [Google Scholar] [CrossRef] [PubMed]
- Qamar, N.; Abbas, N.; Irfan, M.; Hussain, A.; Arshad, M.S.; Latif, S.; Mehmood, F.; Ghori, M.U. Personalized 3D printed ciprofloxacin impregnated meshes for the management of hernia. J. Drug Deliv. Sci. Technol. 2019, 53, 101164. [Google Scholar] [CrossRef]
- Ren, J.; Murray, R.; Wong, C.S.; Qin, J.; Chen, M.; Totsika, M.; Riddell, A.D.; Warwick, A.; Rukin, N.; Woodruff, M.A. Development of 3D Printed Biodegradable Mesh with Antimicrobial Properties for Pelvic Organ Prolapse. Polymers 2022, 14, 763. [Google Scholar] [CrossRef] [PubMed]
- Xue, J.; Wu, T.; Dai, Y.; Xia, Y. Electrospinning and Electrospun Nanofibers: Methods, Materials, and Applications. Chem. Rev. 2019, 119, 5298–5415. [Google Scholar] [CrossRef] [PubMed]
- Garg, K.; Bowlin, G.L. Electrospinning jets and nanofibrous structures. Biomicrofluidics 2011, 5, 013403. [Google Scholar] [CrossRef] [PubMed]
- Dalton, P.D. Melt electrowriting with additive manufacturing principles. Curr. Opin. Biomed. Eng. 2017, 2, 49–57. [Google Scholar] [CrossRef]
- Ferreira, N.M.; Antoniadi, E.; Silva, A.T.; Silva, A.; Parente, M.; Fernandes, A.; Silva, E. Melt Electrowritten Biodegradable Mesh Implants with Auxetic Designs for Pelvic Organ Prolapse Repair. J. Manuf. Mater. Process. 2025, 9, 111. [Google Scholar] [CrossRef]
- Sterk, S.; Silva, M.E.T.; Fernandes, A.A.; Huß, A.; Wittek, A. Development of new surgical mesh geometries with different mechanical properties using the design freedom of 3D printing. J. Appl. Polym. Sci. 2023, 140, e54687. [Google Scholar] [CrossRef]
- Vaz, M.F.; Martins, J.A.P.; Pinheiro, F.; Ferreira, N.M.; Brandão, S.; Alves, J.L.; Fernandes, A.A.; Parente, M.P.L.; Silva, M.E. Optimizing melt electrowriting prototypes for printing non-medical and medical grade polycaprolactone meshes in prolapse repair. J. Appl. Polym. Sci. 2024, 142, e56408. [Google Scholar] [CrossRef]
- Vaz, M.F.R.; Martins, J.A.P.; Pinheiro, F.; Ferreira, N.M.; Brandão, S.; Alves, J.L.; Fernandes, A.A.; Parente, M.P.L.; Silva, M.E.T. Medical- and Non-Medical-Grade Polycaprolactone Mesh Printing for Prolapse Repair: Establishment of Melt Electrowriting Prototype Parameters. Appl. Sci. 2024, 14, 9670. [Google Scholar] [CrossRef]
- Martins, J.P.; da Silva, E.T.; Fernandes, A.A.; Costa de Oliveira, S. Three-Dimensional Melted Electrowriting Drug Coating Fibers for the Prevention of Device-Associated Infections: A Pilot Study. Bioengineering 2024, 11, 636. [Google Scholar] [CrossRef] [PubMed]
- ISO 1183-1:2025; Plastics—Methods for determining the density of non-cellular plastics—Part 1: Immersion method, liquid pycnometer method and titration method. International Organization for Standardization: Geneva, Switzerland, 2025.
- Scaffaro, R.; Botta, L.; Maio, A.; Gallo, G. Incorporation of an Antibiotic in Poly(Lactic Acid) and Polypropylene by Melt Processing. J. Appl. Biomater. Funct. Mater. 2016, 14, e240–e247. [Google Scholar] [CrossRef] [PubMed]
- de Sousa Martins, P.A.L. Experimental and Numerical Studies of Soft Biological Tissues. Ph.D. Thesis, Faculty of Engineering of the University of Porto, Porto, Portugal, 2010. [Google Scholar]
- Elzein, T.; Nasser-Eddine, M.; Delaite, C.; Bistac, S.; Dumas, P. FTIR study of polycaprolactone chain organization at interfaces. J. Colloid. Interface. Sci. 2004, 273, 381–387. [Google Scholar] [CrossRef] [PubMed]
- Lade, H.; Park, J.H.; Chung, S.H.; Kim, I.H.; Kim, J.-M.; Joo, H.-S.; Kim, J.-S. Biofilm Formation by Staphylococcus aureus Clinical Isolates is Differentially Affected by Glucose and Sodium Chloride Supplemented Culture Media. J. Clin. Med. 2019, 8, 1853. [Google Scholar] [CrossRef] [PubMed]
- Advantages and Disadvantages of FTIR Spectroscopy n.d. Available online: https://www.chemlabgenius.com/advantages-and-disadvantages-of-ftir-spectroscopy/ (accessed on 15 May 2024).
- Bhadra, S. Formulation & process development of azithromycin ophthalmic nanosuspension. Int. J. Pharm. Pharm. Sci. 2013, 5, 490–497. [Google Scholar]
- Sahoo, S.; Chakraborti, C.; Mishra, S.; Nanda, U.; Naik, S. FTIR and XRD investigations of some fluoroquinolones. Int. J. Pharm. Pharm. Sci. 2011, 3, 165–170. [Google Scholar]
- Yassin, A.E.; Albekairy, A.M.; Omer, M.; Almutairi, A.; Alotaibi, Y.; Althuwaini, S.; Alaql, O.A.; Almozaai, S.S.; Almutiri, N.M.; Alluhaim, W.; et al. Chitosan-Coated Azithromycin/Ciprofloxacin-Loaded Polycaprolactone Nanoparticles: A Characterization and Potency Study. Nanotechnol. Sci. Appl. 2023, 16, 59–72. [Google Scholar] [CrossRef] [PubMed]
- Haney, E.; Trimble, M.; Cheng, J.; Vallé, Q.; Hancock, R. Critical Assessment of Methods to Quantify Biofilm Growth and Evaluate Antibiofilm Activity of Host Defence Peptides. Biomolecules 2018, 8, 29. [Google Scholar] [CrossRef] [PubMed]
- Nair, S.; Desai, S.; Poonacha, N.; Vipra, A.; Sharma, U. Antibiofilm Activity and Synergistic Inhibition of Staphylococcus aureus Biofilms by Bactericidal Protein P128 in Combination with Antibiotics. Antimicrob. Agents Chemother. 2016, 60, 7280–7289. [Google Scholar] [CrossRef] [PubMed]
- Høiby, N.; Henneberg, K.; Wang, H.; Stavnsbjerg, C.; Bjarnsholt, T.; Ciofu, O.; Johansen, U.R.; Sams, T. Formation of Pseudomonas aeruginosa inhibition zone during tobramycin disk diffusion is due to transition from planktonic to biofilm mode of growth. Int. J. Antimicrob. Agents 2019, 53, 564–573. [Google Scholar] [CrossRef] [PubMed]
- Bhattacharya, S.; Bir, R.; Majumdar, T. Evaluation of Multidrug Resistant Staphylococcus aureus and their Association with Biofilm Production in a Tertiary Care Hospital, Tripura, Northeast India. J. Clin. Diagn. Res. 2015, 9, DC01-4. [Google Scholar] [CrossRef] [PubMed]
- Oduor, J.M.O.; Onkoba, N.; Maloba, F.; Arodi, W.O.; Nyachieo, A. Efficacy of lytic Staphylococcus aureus bacteriophage against multidrug-resistant Staphylococcus aureus in mice. J. Infect. Dev. Ctries. 2016, 10, 1208–1213. [Google Scholar] [CrossRef] [PubMed]
- Zawadzka, K.; Nowak, M.; Piwoński, I.; Lisowska, K. The Synergy of Ciprofloxacin and Carvedilol against Staphylococcus aureus–Prospects of a New Treatment Strategy? Molecules 2019, 24, 4104. [Google Scholar] [CrossRef] [PubMed]
- Arapović, J.; Kompes, G.; Dedić, K.; Teskeredžić, S.; Ostojić, M.; Travar, M.; Tihić, N.; Delić, J.; Skočibušić, S.; Zekiri-Sivro, M.; et al. Antimicrobial resistance profiles of human Brucella melitensis isolates in three different microdilution broths: The first multicentre study in Bosnia and Herzegovina. J. Glob. Antimicrob. Resist. 2022, 29, 99–104. [Google Scholar] [CrossRef] [PubMed]
- Mursyida, E.; Misfa, O.; Pratiwi, S.B.; Shinde, A. In Vitro Sensitivity Test of Escherichia coli ATCC 25922 to Various Antibiotics with Well Diffusion Method. J. Kesehat. Prima 2023, 17, 42. [Google Scholar] [CrossRef]
- Domingos, M.; Chiellini, F.; Cometa, S.; De Giglio, E.; Grillo-Fernandes, E.; Bártolo, P.; Chiellini, E. Evaluation of in vitro degradation of PCL scaffolds fabricated via BioExtrusion. Part 1: Influence of the degradation environment. Virtual Phys. Prototyp. 2010, 5, 65–73. [Google Scholar] [CrossRef]
- Banerjee, A.; Chatterjee, K.; Madras, G. Enzymatic degradation of polycaprolactone–gelatin blend. Mater. Res. Express 2015, 2, 045303. [Google Scholar] [CrossRef]

| Parameter | Value |
|---|---|
| Voltage | 3.23 kV |
| Temperature | 195 °C |
| Height | 3 mm |
| Speed | 825 mm/min |
| Variables | Pore Size (mm) | σmax comfort zone (MPa) |
|---|---|---|
| 240 µm diameter meshes | 1.5 | 1.84 |
| 2.0 | 1.35 | |
| Restorelle® | 2.0 | 3.62 |
| Vaginal Tissue | _________ | 0.56 |
| MSSA ATCC 29213 | MRSA ATCC 43300 | E. coli ATCC 25922 | |
|---|---|---|---|
| Control | 0 mm | 0 mm | 0 mm |
| PCL–Az | 35 mm | 0 mm | 0 mm |
| PCL–Cipro | 26 mm | 29 mm | 39 mm |
| PCL–GS | 31 mm | 0 mm | 31 mm |
Disclaimer/Publisher’s Note: The statements, opinions and data contained in all publications are solely those of the individual author(s) and contributor(s) and not of MDPI and/or the editor(s). MDPI and/or the editor(s) disclaim responsibility for any injury to people or property resulting from any ideas, methods, instructions or products referred to in the content. |
© 2025 by the authors. Licensee MDPI, Basel, Switzerland. This article is an open access article distributed under the terms and conditions of the Creative Commons Attribution (CC BY) license (https://creativecommons.org/licenses/by/4.0/).
Share and Cite
Martins, J.P.; de Sousa, A.S.; Costa de Oliveira, S.; Fernandes, A.A.; Teixeira da Silva, E. Antibiotic-Coated Melt Electrowritten Polycaprolactone Meshes: Fabrication and In Vitro Antibacterial Evaluation. Macromol 2025, 5, 33. https://doi.org/10.3390/macromol5030033
Martins JP, de Sousa AS, Costa de Oliveira S, Fernandes AA, Teixeira da Silva E. Antibiotic-Coated Melt Electrowritten Polycaprolactone Meshes: Fabrication and In Vitro Antibacterial Evaluation. Macromol. 2025; 5(3):33. https://doi.org/10.3390/macromol5030033
Chicago/Turabian StyleMartins, Joana Pinheiro, Ana Sofia de Sousa, Sofia Costa de Oliveira, António Augusto Fernandes, and Elisabete Teixeira da Silva. 2025. "Antibiotic-Coated Melt Electrowritten Polycaprolactone Meshes: Fabrication and In Vitro Antibacterial Evaluation" Macromol 5, no. 3: 33. https://doi.org/10.3390/macromol5030033
APA StyleMartins, J. P., de Sousa, A. S., Costa de Oliveira, S., Fernandes, A. A., & Teixeira da Silva, E. (2025). Antibiotic-Coated Melt Electrowritten Polycaprolactone Meshes: Fabrication and In Vitro Antibacterial Evaluation. Macromol, 5(3), 33. https://doi.org/10.3390/macromol5030033

